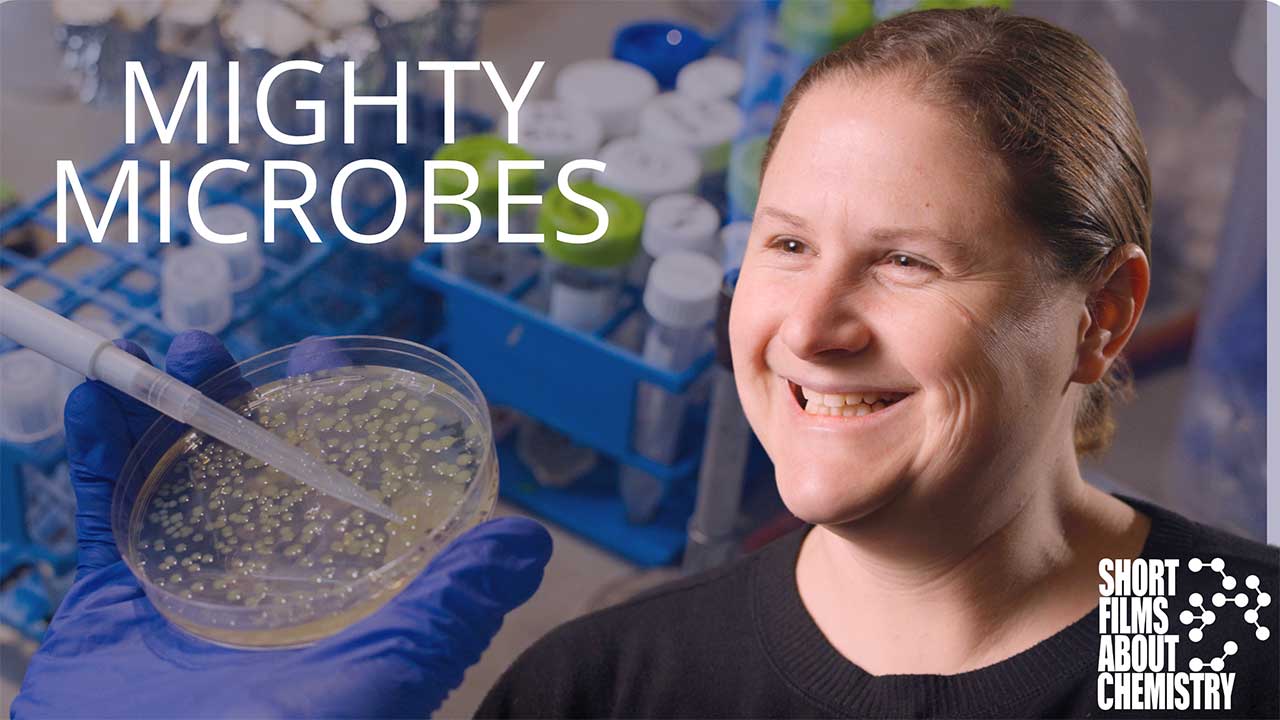

Chemistry Shorts® communicating the breadth & depth of chemistry’s impact on humankind
The Chemistry Shorts® series shows the vital role the chemical sciences play in the biggest issues facing the world. Each film is accompanied by a lesson plan to integrate the science behind these innovations into the classroom.
Other Films in the Series:
“Energy to Spare,” a seven-minute film from Chemistry Shorts®, uses exploding batteries, bowling showdowns, and electrifying animations to give a primer on how batteries work and explore how scientists are revolutionizing battery technology for the renewable energy age.
“Mighty Microbes,” a nine-minute film from Chemistry Shorts®, explores new, self-assembling polymer coatings that help create chemical “suits of armor” for microbes, giving problem-solving scientists the ability to transport them to wherever they need to go.
Driving Reactions
with Hal Alper, University of Texas at Austin, and Frances Arnold, the California Institute of Technology
Our world faces climate, economic, and sustainability challenges that we don’t yet have the tools to fix. The nine-minute film “Driving Reactions” explores how directed evolution and the chemical sciences are creating some of these new tools.
Untapped Potential
with Meagan Mauter, Stanford University; David Sedlak, UC Berkeley; and William Tarpeh, Stanford University
Direct Air Capture & The Future of Climate Change
with Christopher Jones, Georgia Institute of Technology
Global climate change is one of the most important challenges of our time, and chemists and chemical engineers are at the forefront of this effort. One especially promising technology is Direct Air Capture.
The CRISPR-Cas9 technology, and the subsequent research-based innovations stemming from its discovery, integrate chemistry and evolution to program and re-program biology. David Liu’s lab has taken the basics of CRISPR and innovated the technology from cutting DNA to actually chemically swapping its component base pairs.
Stanford chemical engineers have created a synthetic skin that can stretch like rubber, carry electricity, and self-heal. Working with chemical bonds, Zhenan Bao’s lab has chemically developed an entirely new class of synthetic polymers in order to create a highly functional replication of human skin.
Héctor Abruña, Cornell University (2025 Dreyfus Prize Recipient)
Esther Sans Takeuchi, At the Heart of Innovation (powering today’s lifesaving implantable cardioverter defibrillators (ICDs)
Gleb Yushin, How to Get Started on Big Problems (The Blind Ambition Podcast with Jack Kelly)
ACS Reactions (chemistry science videos and infographics)
ACS ChemMatters Magazine (articles that connect chemistry concepts and the real world)
AACT Classroom Resources (chemistry teaching resources)
AIChE K-12 Community (chemical engineering teaching resources and events)
ChemTalk (resources for learning about and teaching chemistry)
Nilay’s Chemistry (videos about foundational chemistry concepts)
LabXchange (teaching resources for science)
HHMI’s Biointeractive (interactive biology lesson and videos)
LabX’s “Chemists in the Kitchen” (videos about cooking and chemistry)
Jonte Lee (kitchen chemistry lessons)
The Artificial Leaf (artificial photosynthesis)
A Crash Course in Organic Chemistry (by Jakob Magolan)
“Forgotten Genius” (the story of pioneering chemist Percy Julian)
“The Poison Squad” (chemistry’s role in food safety)
“Human Nature” (CRISPR-Cas9 documentary)
Dreyfus Foundation on YouTube (Teacher-Scholar profiles and Dreyfus symposia)